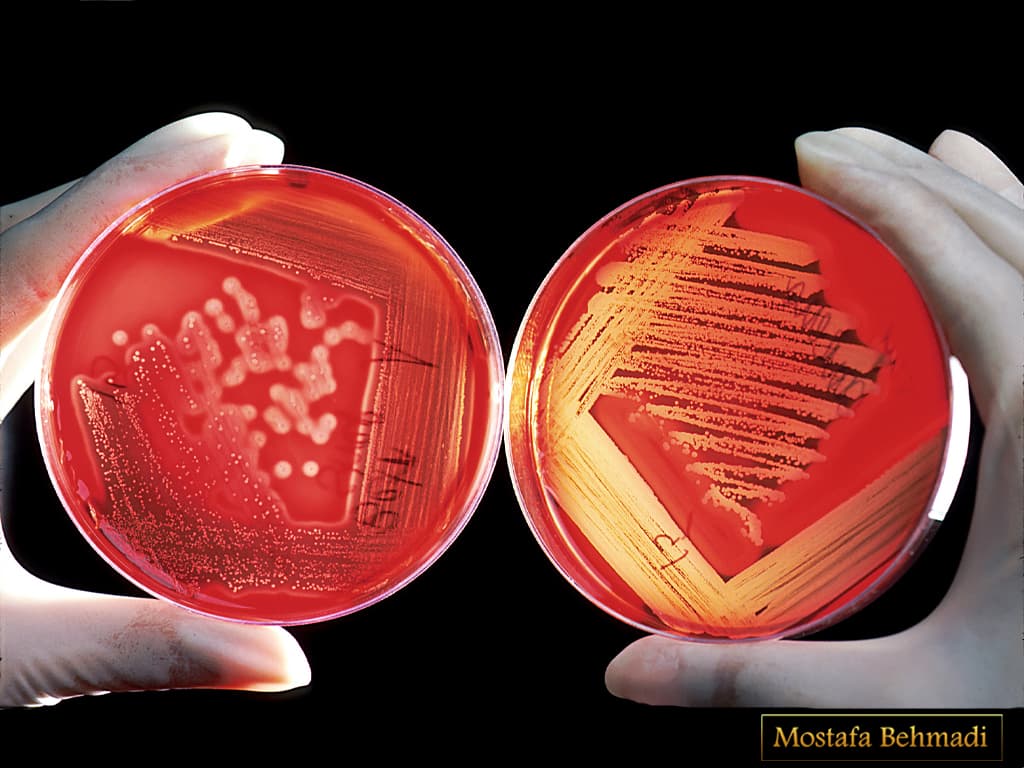
شرایط لازم برای آزمایش عفونت ادراری در خانم ها
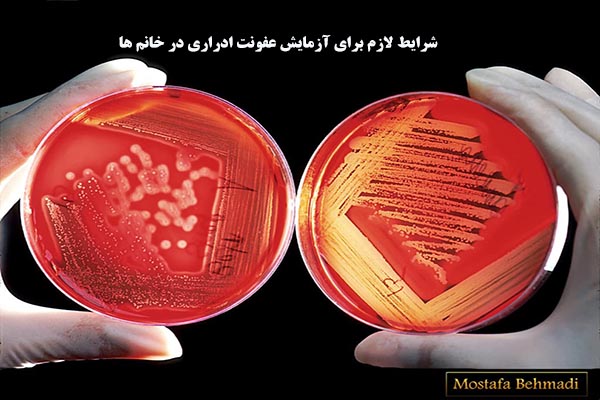
شرایط لازم برای آزمایش عفونت ادراری در خانم ها

شرایط لازم برای آزمایش عفونت ادراری در خانم ها
توجه به این نکته که رعایت شرایط قبل از نمونه گیری بسیار حیاتی است اصلا قابل اغماض نیست. در صورت عدم رعایت شرایط قبل از نمونه گیری قطعا منجر به تشخیص اشتباه و متعاقب آن درمان اشتباه و در نهایت با عوارض عفونت ادراری مواجه خواهید شد.
لطفا قبل از انجام نمونه گیری موارد زیر را مطالعه فرمائید:
- مشخصات ثبت شده بر روی برچسب نمونه را کنترل نمائید تا صحیح باشد.
- نمونه ادرار را فقط در ظرف یکبار مصرف و استریل که آزمایشگاه در اختیارتان قرار می دهد جمع آوری نمائید.
- ابتدا دست خود را با آب و صابون شستشو دهید. پیشابراه خود را با آب گرم و صابون شستشو دهید، در خانم ها شستشو می بایست از جلو به عقب یعنی از واژن به سمت مقعد باشد، کمی منتظر بمانید تا خشک شود اول ادرار خود را دور ریخته ، وسط ادرار را حداقل 30 میلی لیتر (نصف ظرف) درون ظرف بریزید، درب ظرف را بسته و در محل مخصوص در آزمایشگاه قرار دهید. بهتر است ادرار اول صبح را جهت کشت ارار جمع آوری کنید.
- اگر ادرار را خارج از آزمایشگاه تهیه کردید و نمی توانید نمونه را در اسرع وقت به آزمایشگاه منتقل کنید نمونه را با درب بسته در یخچال (8-2 درجه سانتیگراد) نگهداری نموده و بعد از آن در اسرع وقت به آزمایشگاه منتقل نمائید.
- اگر از آنتی بیوتیک ، پماد، کرم یا داروی خاصی استفاده می کنید قبل از نمونه گیری آزمایشگاه را مطلع سازید.
- جهت انجام کشت های میکروبی از جمله کشت ادرار می بایست حداقل یک هفته از آخرین مصرف داروی آنتی بیوتیک گذشته باشد مگر در مواردی که با اطلاع پزشک معالج بیمار می باشد.
- توجه شما به نکات یاد شده باعث افزایش صحت و دقت جواب آزمایش خواهد شد.
اگه دوست دارید مطالب آزمایشگاهی رو به زبان ساده ای آموزش ببینید از پیج اینستاگرام ما بازدید کنید.

بدون دیدگاه